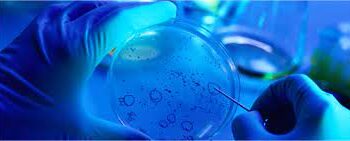
مخلوق صغير غريب لديه قواسم مشتركة مع أسلاف النمل

كايرون .. مفتاحك السحري
أغسطس 9, 2021
قصيدة “بكيت حتى انتهت الدموع” لنزار قباني
مايو 16, 2021
أهم الزوايا ( السمات) في الخريطة الفلكية
أكتوبر 28, 2021
اكتمال القمر في برج العقرب
أبريل 26, 2021
شخص يفهمك بعمق … لكنه لا يشبهك: من هو الـ Dark Empath ؟
أكتوبر 18, 2025
الحب .. جهلٌ مؤقت
أغسطس 1, 2025
منتخب سوريا يلتقي نظيره البحريني ببطولة قيرغيزستان .. غداً
يوليو 19, 2025